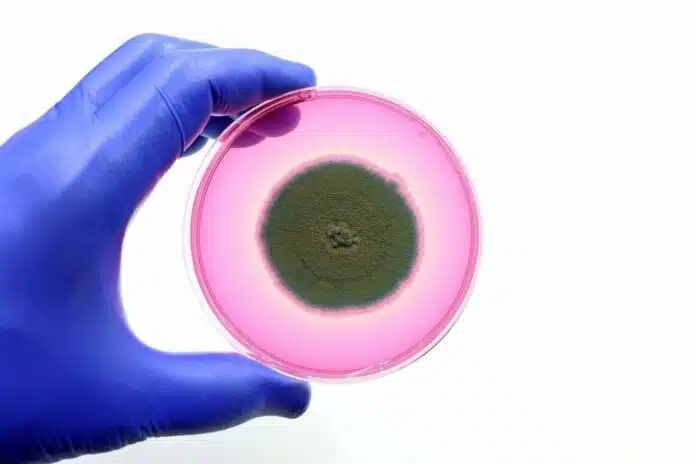

Το Candida auris έχει μολύνει εκατοντάδες ασθενείς στα ελληνικά νοσοκομεία, με τα κρούσματα να αυξάνονται ανησυχητικά τα τελευταία χρόνια
Συναγερμός για τη δημόσια υγεία στα ευρωπαϊκά νοσοκομεία προκαλεί ο Candida auris, ένας μύκητας που εμφανίζει αντοχή στα αντιμυκητιασικά φάρμακα και εξαπλώνεται ταχύτατα σε νοσοκομειακές δομές, προκαλώντας σοβαρές λοιμώξεις σε ήδη ευάλωτους ασθενείς. Το ECDC (Ευρωπαϊκό Κέντρο Πρόληψης και Ελέγχου Νοσημάτων) προειδοποιεί ότι πλέον δεν πρόκειται για μεμονωμένα περιστατικά, αλλά για μια σταθερή απειλή στο περιβάλλον των νοσοκομείων.
Από το 2013 έως το 2023 έχουν καταγραφεί πάνω από 4.000 κρούσματα στην Ευρώπη, με 1.346 νέες λοιμώξεις μόνο το 2023. Η Ιταλία είναι ανάμεσα στις πιο πληγείσες χώρες, με 712 κρούσματα, πίσω από την Ισπανία (1.807) και την Ελλάδα (852). Η ταχεία εξάπλωση δείχνει ότι ο μύκητας δεν αποτελεί πλέον περιστασιακή απειλή, αλλά έχει εγκατασταθεί μόνιμα στα νοσοκομεία.

Μύκητας ανθεκτικός και δύσκολα περιορίσιμος
Η επικινδυνότητα του C. auris οφείλεται κυρίως σε δύο χαρακτηριστικά:
- Αντοχή στα αντιμυκητιασικά φάρμακα, που μειώνει την αποτελεσματικότητα των θεραπειών.
- Δυνατότητα μακράς επιβίωσης σε επιφάνειες και ιατρικά εργαλεία, διευκολύνοντας τη μετάδοση από ασθενή σε ασθενή.
Τα συμπτώματα είναι συχνά μη ειδικά και περιλαμβάνουν πυρετό και ρίγη, ενώ οι λοιμώξεις μπορεί να επηρεάσουν το αίμα, τραύματα ή άλλα όργανα. Η έγκαιρη διάγνωση απαιτεί εξειδικευμένες εργαστηριακές εξετάσεις, καθιστώντας δύσκολο τον έλεγχο χωρίς κατάλληλα τεστ.
Ο C. auris πρωτοεντοπίστηκε στην Ιαπωνία το 2009 και για πρώτη φορά στην Ευρώπη το 2014. Πρόσφατα έχουν αναφερθεί εστίες σε Κύπρο, Γαλλία και Γερμανία, ενώ σε Ιταλία, Ελλάδα, Ρουμανία και Ισπανία η μετάδοση είναι πλέον τόσο εκτεταμένη που δεν είναι δυνατόν να διακριθούν μεμονωμένα κρούσματα.
Το ECDC επισημαίνει τη διάσπαρτη αντίδραση των ευρωπαϊκών συστημάτων υγείας: μόνο 17 από τις 36 χώρες διαθέτουν εθνικό σύστημα επιτήρησης, 15 χώρες έχουν οδηγίες για πρόληψη και έλεγχο λοιμώξεων, ενώ 29 διαθέτουν κέντρα αναφοράς μυκητολογίας και 23 προσφέρουν εργαστηριακές δοκιμές επιβεβαίωσης στα νοσοκομεία. Χωρίς συστηματική αναφορά και κοινές στρατηγικές, η πραγματική έκταση του προβλήματος είναι πιθανώς υποεκτιμημένη.
Η προειδοποίηση του Έλληνα Επιστήμονα στο ECDC

Ο Διαμαντής Πλαχούρας, υπεύθυνος για τις Αντιμικροβιακές Αντοχές και τις λοιμώξεις που σχετίζονται με τη φροντίδα υγείας στο ECDC, δηλώνει: «Ο C. auris εξαπλώθηκε μέσα σε λίγα χρόνια, από μεμονωμένα περιστατικά σε ένα φαινόμενο εδραιωμένο σε ορισμένες χώρες. Η έγκαιρη ανίχνευση και ο συντονισμένος έλεγχος των λοιμώξεων μπορούν ακόμη να περιορίσουν τη μετάδοση.»
Οι ειδικοί προειδοποιούν ότι χωρίς κοινές στρατηγικές, άμεσους ελέγχους και επαρκείς πόρους, ο Candida auris μπορεί να εγκατασταθεί μόνιμα στα ευρωπαϊκά νοσοκομεία, αποτελώντας μια νέα κρίση δημόσιας υγείας, όπως έχει ήδη συμβεί σε άλλες περιοχές του κόσμου.
Η τραγική εικόνα στην Ελλάδα
Βάσει όσων αναγράφονται στην έρευνα του ECDC, ο μύκητας Candida auris, εμφανίστηκε για πρώτη φορά στην Ελλάδα το 2019, όταν καταγράφηκαν τρία κρούσματα. Έκτοτε, η εξάπλωση του συγκεκριμένου παθογόνου είναι ραγδαία: το 2020 καταγράφηκαν 13 κρούσματα, το 2021 καταγράφηκαν 58 κρούσματα, το 2022 καταγράφηκαν 327 κρούσματα, το 2023 καταγράφηκαν 451 κρούσματα και το 2024 καταγράφηκαν 852 κρούσματα.

Σε ότι αφορά την Ελλάδα, στην έρευνα αναγράφεται πως «κατά την επίσκεψη του ECDC στην Ελλάδα τον Απρίλιο του 2024, το C. auris είχε εξαπλωθεί σε όλο το σύστημα υγείας, με εκατοντάδες κρούσματα να έχουν εντοπιστεί σε διάφορα νοσοκομεία». Μάλιστα, «ένα κέντρο αποκατάστασης που επισκέφθηκε το ECDC είχε δεχθεί τόσο μεγάλο αριθμό ασθενών που είχαν ήδη αποικιστεί ή μολυνθεί με C. auris από νοσοκομεία, ώστε ήταν απαραίτητο να οριστεί ένας ειδικός χώρος για τη φροντίδα τους».
Σύμφωνα με μια μελέτη – ορόσημο στην οποία συμμετείχαν 500 ερευνητές από όλο τον κόσμο -και από τη χώρα μας- και η οποία δημοσιεύθηκε τον Σεπτέμβριο του 2024 στο επιστημονικό περιοδικό Lancet, υπολογίζεται πως έως το 2050, θα πεθάνουν περισσότεροι από 39 εκατομμύρια άνθρωποι εξαιτίας των υπερβακτηρίων. Πρόκειται για κάτι που σύμφωνα με την έρευνα, οφείλεται στη μη αποτελεσματικότητα των αντιβιοτικών, εξαιτίας της αλόγιστης χρήσης τους. Αξίζει να σημειωθεί πως σύμφωνα με την έρευνα, περίπου το 75% των λοιμώξεων που οφείλονται στη μικροβιακή αντοχή, συνδέονται με νοσοκομειακές λοιμώξεις.
Ιδιαιτέρως αποθαρρυντικά είναι τα δεδομένα που αφορούν και τη χώρα μας. Σύμφωνα με έρευνα του ECDC που δημοσιεύθηκε το 2023, η Ελλάδα παρέμενε πρώτη σε θανατηφόρες λοιμώξεις στην Ε.Ε. εξαιτίας ανθεκτικών ή πολυανθεκτικών μικροβίων, καταγράφοντας 20 θανάτους ανά 100.000 κατοίκους. Το ακόμη χειρότερο είναι πως σύμφωνα με την έρευνα που δημοσιεύθηκε στο Lancet, εφόσον δεν υπάρξει κάποια δραστική αλλαγή τα επόμενα χρόνια, η Ελλάδα θα συγκαταλέγεται το 2050 στις ελάχιστες χώρες παγκοσμίως όπου θα καταγράφονται περισσότεροι από 30 θάνατοι ανά 100.000 κατοίκους.
cibum.gr